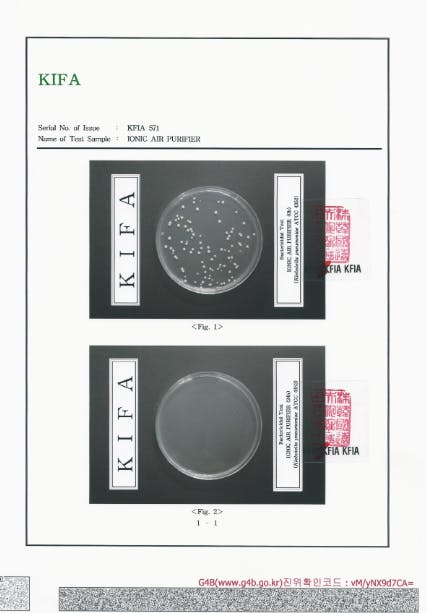

皆様おはようございます!今週一週間も猛暑に負けずに頑張ってください!さて、昨夜も気温が30度もあり、暑い夜でしたね、仕方なく朝から夜までクーラーは付けっ放しの家庭が多いと思いますが室内空気の汚れ気になりませんか?湿度も高く涼しいけど何となくミストサウナにいるような気分になりますね、湿度が60%以上になりますとカビなどの繁殖も活発になり注意が必要です。
そこでイオニスプラグが約2000万個のマイナスイオンの力によって空気中の水分と結合することによりカビ菌はもちろん匂いなどの状況にも効果的です。朝の掃除機の時にのみ換気だけでも1日中快適に過ごせると思いますので是非とも皆様も体験して見てください!
韓国政府公認検査機関からの空気中のバクテリア除去試験データーからもその性能がわかります。

より詳しい資料は下記の公式ホームページからもご覧ください!
https://ionicjp2022.wordpress.com/



